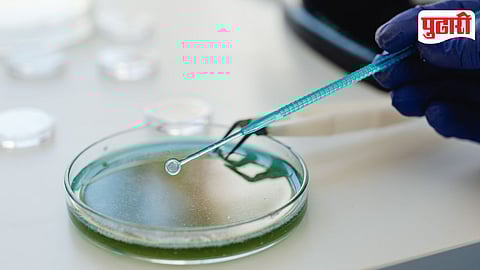
Water Sample

पिंपरी: पिंपरी-चिंचवड शहरातील पवना, इंद्रायणी आणि मुळा या तिन्ही नद्यांचे प्रदूषण वाढल्याच्या तक्रारी शहरातील पर्यावरणप्रेमी नागरिकांनी केल्या आहेत. त्यामुळे केंद्रीय प्रदूषण नियंत्रण मंडळाच्या पथकाने तिन्ही नद्यांचे पाणी तपासणीसाठी घेतले आहेत. नद्यांच्या पाण्याची गुणवत्ता तपासून त्यावर प्रभावी उपाययोजना करण्यासाठी केंद्रीय प्रदूषण मंडळाच्या पथकाकडून अहवाल दिला जाणार आहे.
शहराच्या हद्दीतून पवना नदीची लांबी 24.40 किलोमीटर, इंद्रायणी नदीची लांबी 20.60 किलोमीटर आणि मुळा नदीची लांबी 12.40 किलोमीटर आहे. शहरातील नदी प्रदूषणाचा प्रश्न दिवसेंदिवस गंभीर होत चालला आहे. शहरातील नाल्यांद्वारे मैलासांडपाणी, तसेच कारखान्यांचे रसायनयुक्त सांडपाणीही थेट नदीत मिसळते. शहरीकरणामुळे पवना, इंद्रायणी व मुळा नदीचे प्रदूषण वाढले आहे.
लवकरच अहवाल प्राप्त होणार
पवना नदी किवळेपासून ते दापोडीपर्यंत, इंद्रायणी नदी तळवडेपासून, तर आळंदीपर्यंत आणि मुळा नदी वाकडपासून दापोडीपर्यंत प्रदूषित होत असल्याचे आढळून आले आहे. दरम्यान, शहरातील पर्यावरणप्रेमी नागरिकांकडून नद्याचे प्रदूषणावर उपाययोजना करण्यासाठी सातत्याने पाठपुरावा सुरू आहे. अनेक पर्यावरणप्रेमी नागरिकांनी प्रदूषणाबाबत तक्रारी केलेल्या आहेत.
त्यानुसार नद्याचे प्रदूषण आणि पाण्याची गुणवत्ता तपासण्यासाठी केंद्रीय प्रदूषण नियंत्रण मंडळाकडून शहरातील पवना, इंद्रायणी व मुळा नद्याच्या पाण्याचे नमुने नुकतेच घेण्यात आले आहेत. लवकरच या नमुने तपासणीचा अहवाल प्राप्त होणार असून, त्यातून नदी प्रदूषणाची पातळी आणि स्थिती समोर येणार आहे.
नद्यांचे आरोग्य बिघडले
शहरातून वाहणारी पवना नदी देशातील सर्वांधित प्रदूषित नदी असल्याचा निष्कर्ष प्रदूषण मंडळाने गतवर्षी दिला होता. महापालिका आणि राज्य प्रदूषण मंडळाने यापूर्वी पवना नदीवर 25 ठिकाणी, इंद्रायणी नदीवर 12 ठिकाणी, मुळा नदीवर 10 ठिकाणी उन्हाळा, पावसाळा आणि हिवाळा या तीनही ऋतूंत पाण्याचे नमुने घेऊन प्रदूषणाच्या नोंदी घेतल्या. त्यात शहरातील नद्यांचे आरोग्य बिघडले असल्याची माहिती समोर आली आहे.